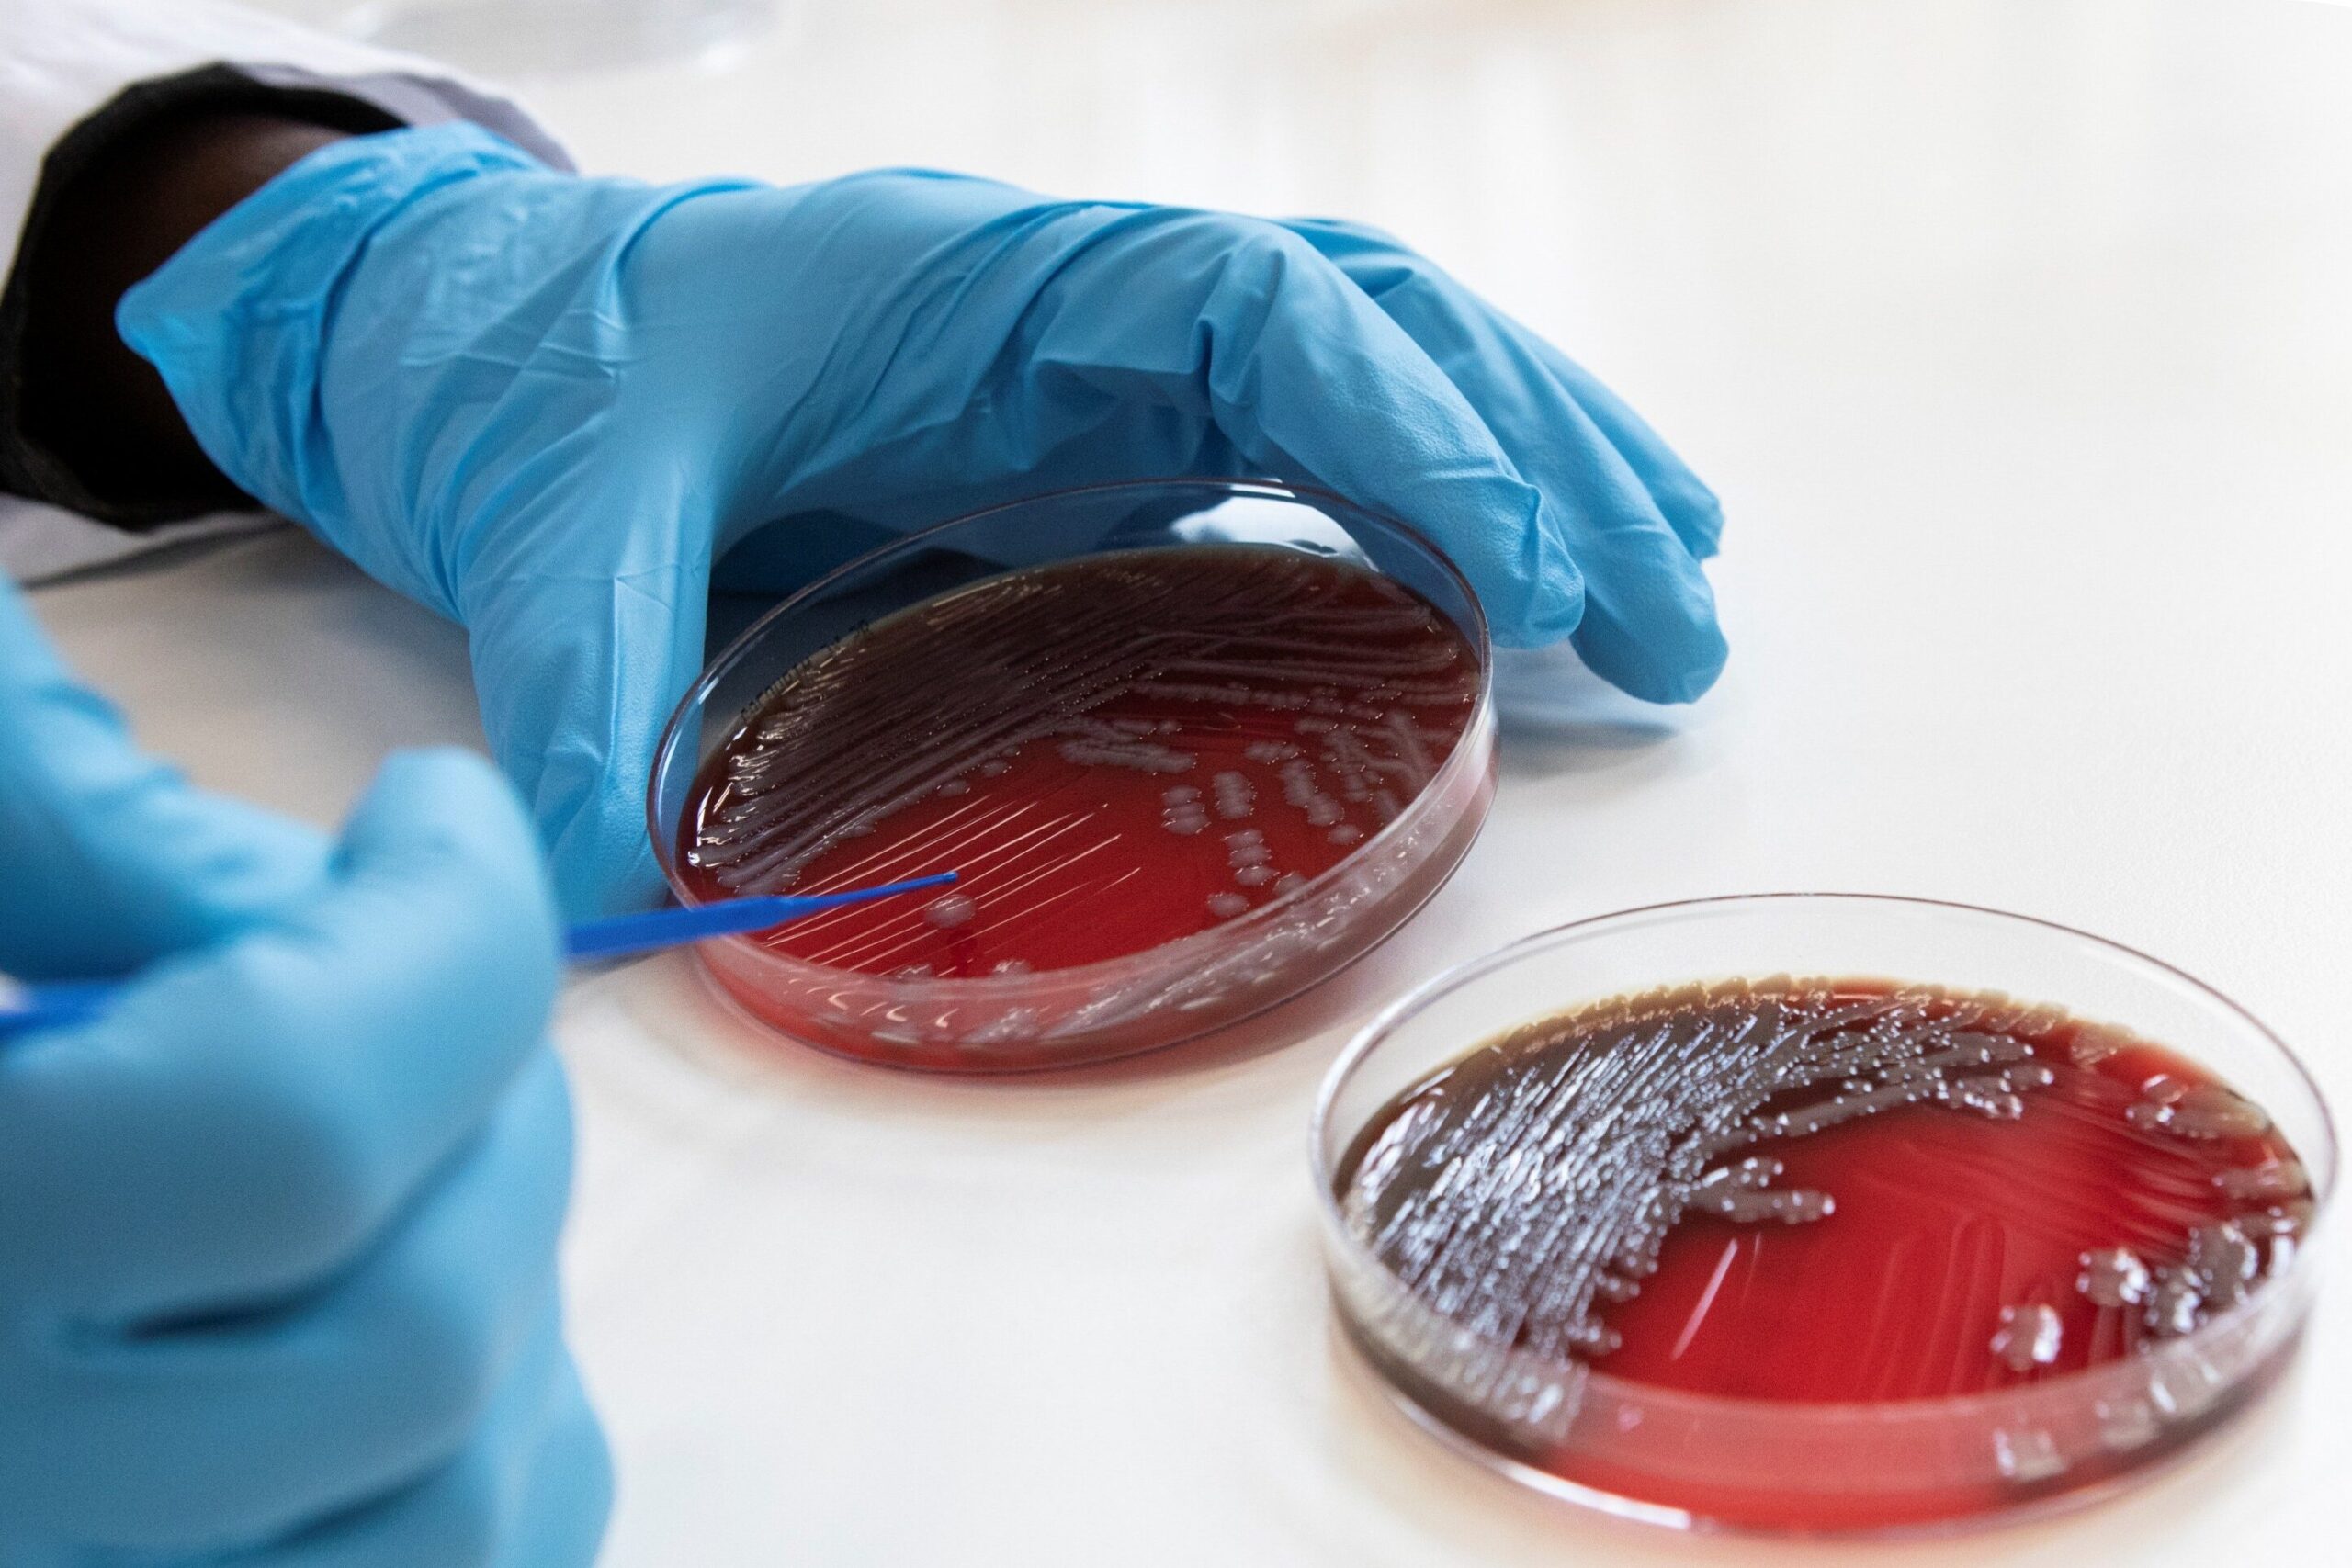

Libérer l’accès aux
ressources techniques
en microbiologie
Notre objectif est d’améliorer l’accès aux ressources techniques à l’échelle mondiale, afin de maximiser l’efficacité des diagnostics microbiologiques existants.
L’Alliance mondiale pour la microbiologie (GAM) est une collaboration à but non lucratif créée et soutenue par de nombreuses ONG, institutions universitaires, partenaires techniques et professionnels. Nous nous engageons à adopter une approche collaborative pour examiner, valider et mettre à disposition en libre accès (en ligne et hors ligne) les ressources techniques existantes en matière de diagnostic microbiologique.
La GAM a été lancée en 2024 par des scientifiques partageant les mêmes idées afin d’améliorer l’accès à des procédures microbiologiques de qualité, évaluées par des pairs. Bien que la nécessité de disposer d’outils de laboratoire standardisés et en libre accès soit reconnue depuis longtemps, il n’existe aucun référentiel mondial évalué par des pairs pour sélectionner, approuver et diffuser ces ressources en vue d’une utilisation courante dans les laboratoires des pays à revenu faible et intermédiaire (PRFI). La GAM s’efforce de changer cela !
Au cours des prochains mois, ce site web sera enrichi de procédures de laboratoire évaluées et approuvées par GAM, qui pourront être adaptées à votre contexte et à vos besoins.
Vision
Renforcer la pratique des laboratoires de microbiologie dans les pays à revenu faible et intermédiaire (PRFI), afin d’améliorer la prévention, le diagnostic, la prise en charge et la surveillance des principales maladies infectieuses.
Mission
Fournir une plateforme collaborative pour l’examen technique, la validation et la diffusion d’outils pratiques existants visant à mettre en place et à pérenniser des analyses microbiologiques de haute qualité, dans les domaines suivants :
- Microbiologie diagnostique, en mettant initialement l’accent sur la détection, l’identification et les tests de sensibilité aux antimicrobiens (AST) en bactériologie et en mycologie
- Prélèvement d’échantillons, sélection des tests, interprétation des résultats, communication des résultats et systèmes d’information de laboratoire associés
- Systèmes de gestion de la qualité pour les tests microbiologiques
- Renforcement des capacités en ressources humaines et évaluation des compétences
- Identification et promotion d’initiatives efficaces de renforcement des laboratoires
- Production locale de milieux de culture et de réactifs de qualité
- Procédures post-analytiques, y compris la communication des résultats, la liaison avec les cliniciens, la surveillance de la résistance aux antimicrobiens et les indicateurs clés de performance des laboratoires en microbiologie
Gouvernance
GAM est dirigé par un comité de pilotage inaugural, composé actuellement de six membres. Deux membres supplémentaires, seront recrutés d’ici 2026. Le comité de pilotage sera renouvelé chaque année ; à partir de 2027, deux membres seront remplacés lors de la réunion annuelle des membres de GAM à l’ESCMID Global.
